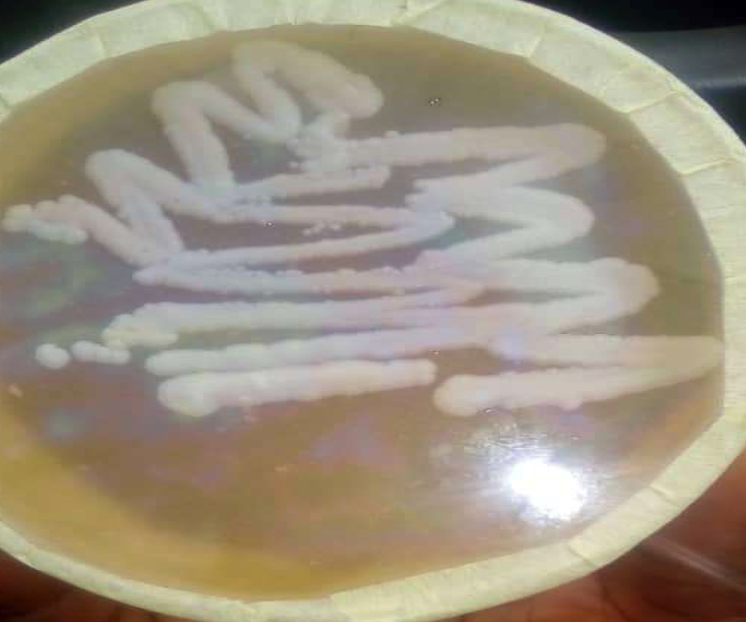
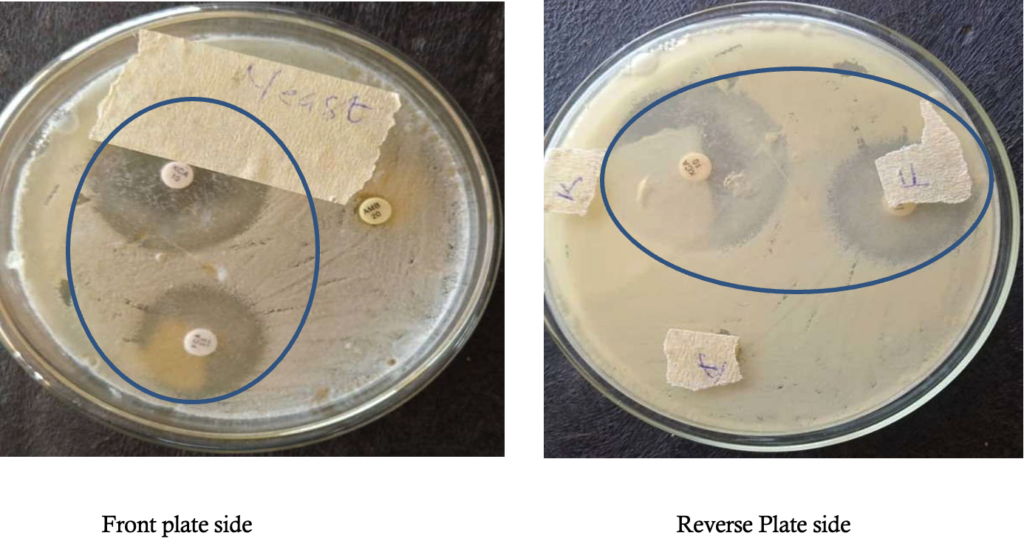

Case Report | Open Access | Volume 8 (4): Article 82 | Published: 08 Oct 2025
In vitro and in vivo ketoconazole sensitivity disparity in a cutaneous candidiasis case of Kluyveromyces marxianus: A case report
Menu, Tables and Figures
On Pubmed
On Google Scholar
Navigate this article
Tables
| Antifungal | Zone of inhibition (duplicate) | Mean ± SD |
|---|---|---|
| Ketoconazole | 39 (38) | 38.5 ± 0.5 |
| Fluconazole | 25 (24) | 24.5 ± 0.5 |
| Amphotericine B | 0 (0) | 0 |
Table 1: Mean and standard deviation of the susceptibility test Results
Figures














Keywords
- Yeast
- non-Candida albicans
- Cutaneous candidiasis
- Case report
- Kluyveromyces marxianus
Chioma Nnenna Nwofor&
Microbiology Department, Imo State University, Owerri, Nigeria
&Corresponding author: Chioma Nnenna Nwofor, Microbiology Department, Imo State University, Owerri, Nigeria, Email: chiomanwofor@gmail.com ORCID: https://orcid.org/0000-0003-3687-0668
Received: 30 Apr 2025, Accepted: 07 Oct 2025, Published: 08 Oct 2025
Domain: Antimicrobial Resistance
Keywords: Yeast, non-Candida albicans, Cutaneous candidiasis, Case report, Kluyveromyces marxianus
©Chioma Nnenna Nwofor. Journal of Interventional Epidemiology and Public Health (ISSN: 2664-2824). This is an Open Access article distributed under the terms of the Creative Commons Attribution International 4.0 License (https://creativecommons.org/licenses/by/4.0/), which permits unrestricted use, distribution, and reproduction in any medium, provided the original work is properly cited.
Cite this article: Chioma Nnenna Nwofor. In vitro and in vivo ketoconazole sensitivity disparity in a cutaneous candidiasis case of Kluyveromyces marxianus: A case report. Journal of Interventional Epidemiology and Public Health. 2025;8(4):82. https://doi.org/10.37432/jieph-d-25-00108
Abstract
Introduction: Cutaneous candidiasis is an infection caused by the yeast, Candida albicans or other Candida-related species. Recently, Candida infections of the skin have become more prevalent and could be attributed to an increase in the number of immunocompromised individuals. Kluyveromyces marxianus (formerly Candida kefyr) is a rare yeast and a less common cause of cutaneous infection in humans, although it is usually associated with invasive candidiasis, especially among immunocompromised patients.
Case summary: A case of cutaneous candidiasis on a 49-year-old adult male patient was evaluated. Laboratory examinations were conducted, including morphological identification, gram staining and molecular identification using Polymerase Chain Reaction (PCR), and gene sequencing. An antifungal susceptibility test was carried out using conventional drugs. Morphological identification revealed the presence of yeast as the most predominant isolate, while molecular and gene sequencing identified the isolate as Kluveromyces marxianus. Antifungal susceptibility test against ketoconazole, fluconazole and Amphotericin B showed a zone of inhibition with mean (± SD) of 38.5 (±0.5mm), 24.5 (±0.5mm) and 0 (±0.0mm), respectively. The patient was treated with both oral and topical ketoconazole but showed no complete therapeutic clearance of the lesion after four months of therapy.
Conclusion: This study revealed an in vitro and in vivo ketoconazole sensitivity disparity in a case of Kluyveromyces marxianus, a cutaneous non- Candida albicans species. Based on this finding, further study of this pathogen is imminent to mitigate the health implications, especially in developing countries like Nigeria, for effective patient management.
Introduction
Cutaneous candidiasis is an infection caused by the yeast Candida albicans or other Candida-related species, and they usually appears as a superficial infection of the skin and mucous membrane [1]. Some of these infections include diaper dermatitis, erosion interdigitalis blastomycetica, candidal balanitis and perianal dermatitis. Candida genera has over 150 species, some of which include Candida glabrata, C. parapsilosis, C. tropicalis, C. krusei, C. dubliniensis, Kluyveromyces marxianus (formerly Candida kefyr), C. guilliermondi, C. zeylanoides although of all, Candida albicans seems to be more commonly isolated and associated with human infections [2]. Humans harbour yeasts, including Candida species, as part of their normal flora, especially in the mouth, intestinal tract, the mucous membrane, anus and the vagina. Candida species are usually not part of the normal flora of the skin but may colonise the fingers or body folds transiently [3].
Recently, there has been an increase in the prevalence of Candida infections of the skin, and this has been attributed to nutritional deficiencies such as lack of vitamins, endocrine diseases such as diabetes mellitus, hypothyroidism, Cushing syndrome and also amongst immunocompromised individuals, such as individuals exposed to trauma, skin maceration, radiation–induced mucositis and ulcerations [4]. Individuals who are deficient in T-lymphocyte function, such as patients suffering from acquired immune deficiency syndrome (AIDS) tend also to be more vulnerable to cutaneous and mucosal candidiasis [5]. So far, studies have reported cutaneous candidiasis to be more prevalent amongst women than men [6;7], while another study reports that there is actually no difference in the incidence of this disease across gender [1]. Candida species presently are the fourth major cause of bloodstream infections in the United States, especially amongst persons aged 65 years and above [8], while another study reports that the disease affects all age brackets, but most especially infants and the elderly [1]. Lesions of cutaneous candidiasis can be seen at different sites such as the skin folds of the armpit, breast folds, groin, between fingers, toes, intergluteal, glans penis, head, face, nails and on the legs. In treating diseases caused by Candida species, oral or topical antifungal therapy is usually employed, but recently it has been observed that most species have shown high consistent drug–resistance/multidrug-resistance against these therapeutics [9]. Out of all Candida species commonly associated with cutaneous candidiasis, Candida kefyr is usually rare and the least isolated [10,11]. This rare yeast Candida kefyr is presently known as Kluyveromyces marxianus (K. marxianus) and is also known as industrial yeast due to its presence in kefir grain and milk. Aside from dairy products, it has also been found present in tequila and chocolate [12]. This uncommon yeast has been reported to be associated with invasive candidiasis in immunocompromised patients, especially among those suffering from oncohematological diseases [13]. Reports shows that it has been isolated from the hands of health care workers [9], water samples for the first time in Lebanon [12] and also from a 72–year–old woman suffering from cutaneous candidiasis [1]. Recently, a study reported isolating a total of 134 such cases from healthy individuals, patients (HIV/AIDS, hematologic malignancy and diabetes) and dairy products [14]. In yet another study, two cases were retrieved from a patient with systemic candidiasis in Pakistan [15], also in Kuwait, the same fungus was isolated from an immunocompromised patient [13], and another report was also recorded from an invasive case of a COVID-19 patient [16].
In treating infections caused by this rare fungus, some of the different antifungals usually employed include the azoles, polyenes, and echinocandins, which apply different mechanisms of action on the fungus. Recently this uncommon Candida species and emerging pathogen, K. marxianus has been reported by some studies to have expressed different susceptibility patterns to some antifungals such as amphotericin B, ketoconazole, voriconazole, itraconazole and fluconazole [13-15], while different studies have reported a high susceptibility of C. kefyr to amphotericin B from different clinical samples [17, 18] a contrary showed that 10 isolates of K. marxianus expressed low susceptibility to amphotericin B [9]. In a particular study, a case of invasive Candida kefyr infection presenting itself as pyelonephritis in a hospitalised COVID-19 patient reported that the infection was controlled effectively after prolonged administration of fluconazole, although MIC values expressed high susceptibility to amphotericin B [16]. A particular study had reported that K. marxiamus expressed a low susceptibility to Voriconazole[11], while another study reported that K. marxianus expressed a minimum inhibitory concentration (MIC) of 0,5µg/ml on amphotericin B and fluconazole respectively and a much lower MIC concentration of 0.03, 0.06, 0.016, 0.06µg/ml on itraconazole, posaconazole, caspofungin, and micafungin respectively [19]. This rise in the discrepancy of susceptibility by this fungus to different antifungals is of serious concern in the health care community and needs to be addressed. Infections caused by opportunistic yeast such as K. marxianus are on the rise, although limited literature is documented on them. Therefore, this study reports a case of cutaneous candidiasis caused by K. marxianus in a 49- year adult male patient who developed therapeutic resistance to oral and topical antifungal therapy that had earlier expressed inhibition on the isolate in vitro.
Case Summary
In-vitro and in-vivo experiments
In vitro and in vivo studies are common experimental methods normally employed in biology and biochemistry [20]. An in-vitro study is usually performed outside the biological environment (ie, in a glass or tube) while an in-vivo study is carried out within the biological system (ie, living organism) [21]. In-vitro studies have numerous advantages over in-vivo studies, such as being in control of the chemical and physical conditions, being less expensive, reduced animal use and higher throughput, while one of its disadvantages was its inability to provide the exact conditions of a biological environment. On the other hand, the use of biological subjects to evaluate the therapeutic efficacy of drugs has its own associated disadvantages, such as, high cost, time and ethical challenges [22]. A study has shown that there could be different outcomes in the findings of these two experiments [21]. It was reported that the findings of in-vitro studies may not be replicated in the observation of the original organism, while the outcome of in-vivo studies may not actually target the site at which the researcher is interested. He therefore concluded that in situations where in-vitro and in-vivo studies express different results, the disparity can be considered as a significant insight about the target site [21]. One of the major correlations between in vitro and in vivo studies is the bioavailability of drugs. This is determined by the level, rate and extent of drug absorption across living tissues. Although drugs have their physicochemical properties and treatment timelines, a huge role is played out by the anatomical target sites (intestinal and mucosal layer, skin), mode of application (oral, topical, parenteral) and host immune system (co-morbidities, HIV, diabetes, hypertension).
Treatment timeline of Candidiasis using antifungals as provided by the United States Centres for Disease Control and Prevention (CDC)
Candidiasis are treated using antifungal medications, which can come in different forms: oral, creams, gels and intravenous (IV). The type of antifungal employed and duration are dependent on the severity of infection and the patient’s health condition. For vaginal candidiasis (yeast infections), creams are usually applied inside the vagina accompanied by a single dose of fluconazole or ketoconazole [23]. Some examples of vaginal creams include clotrimazole, miconazole, and terconazole, which can be applied for 7 to 14 days. For skin candidiasis, nystatin or ketoconazole, clotrimazole cream can be applied on the affected skin region for 2 -4 weeks. For mouth and throat candidiasis, an antifungal oral gel such as miconazole gel can be applied inside the mouth for 7 -14 days, accompanied by clotrimazole, miconazole or nystatin, although fluconazole can be employed in severe cases. For candidiasis of the oesophagus, fluconazole is usually employed orally or intravenously for 14 to 21 days. In cases of invasive candidiasis, a lot of factors should be considered, such as the patient’s age, health conditions, immune status and severity of infection. For adults, caspofungin or micafungin is given intravenously. Fluconazole, amphotericin B or other antifungals can also be employed through the same route. In cases of bloodstream Candida, treatment should continue after 2 weeks. Other forms of invasive candidiasis, such as infections in joints, bones, central nervous system, will need to be treated for a very long time [24].
Case presentation and physical examination findings
A 49- year adult male patient visited the microbiology laboratory of Imo State University, Owerri, Nigeria, presenting with signs of cutaneous mycoses on his left hand around his third and fourth fingers. The initial lesion was unknown, and the complaint of itching was established, especially when he came into contact with water. At the time the patient visited, he was physically stable, reported a history of cholesterol, which he was managing with control pills and complained of signs of malaria for which he was taking anti-malaria drug LONART DS (Artemether 80mg + Lumefantrine 480mg) marketed by Greenlife Pharmaceutical Limited. Results from physical examination present inflammation and itching of the skin area affected, which is suggestive of cutaneous mycoses (Figure 1).
Diagnostic assessment and findings
Method of sample collection: The infected area on the patient’s hand was first cleaned with disposable swab pads and allowed to evaporate. Afterwards, a sterile swab stick was dipped in normal saline and used to swab the lesion surface. This was done in duplicate.
Culturing technique: The samples were inoculated into duplicate agar plates containing Sabouraud Dextrose Agar (SDA) (Oxoid brand, England) supplemented with 250mg of chloramphenicol to inhibit bacteria growth and later incubated at 25 – 30 ºC for 2 -5 days to allow growth of the organism.
Microscopic examination of samples: The culture was observed morphologically to be yeast cells, and they were examined microscopically using lactophenol cotton blue as described by Chesbrough [25] and Gram-stained accordingly.
Observation from one of the duplicate culture plates revealed minimal growth of mold, suggestive of Aspergillus species, which was considered not significant when compared with the other colonies with heavy growth of white shiny yeast on both plates. Pure culture of the yeast colony was prepared (Figure 2). Afterwards, gram staining of the yeast was carried out, and purple oval budding cells were observed (Figure 3).
Molecular identification of isolate: For clarification of the isolate, it was further analyzed using molecular methods of identification. This was carried out at the medical laboratory department at Niger Delta University, Wilberforce Island, Bayelsa State, Nigeria. The DNA of the yeast isolate was extracted using a ZR fungal DNA mini prep extraction kit supplied by Inqaba South Africa and quantified using nanodrop 1000 spectrophotometer [26]. The internal transcribed spacer (ITS) region of the rRNA genes of the isolates were amplified using the ITS1F:5′-CTTGGTCATTTAGAGGAAGTAA3′ and ITS4: 5′ TCCTCCGCTTATTGATATGC-3̕ primers on ABI 9700 Applied Biosystems thermal cycler at a final volume of 30 microlitres for 35 cycles. The PCR mix included: the x2 Dream Taq master mix supplied by Inqaba, South Africa (Taq polymerase, DNTPs, MgCl), the primers at a concentration of 0.4M and the extracted DNA as template. Sequencing was done using the BigDye Terminator kit on a 3510 ABI sequencer by Inqaba Biotechnological, Pretoria South Africa. Obtained sequences were edited using the bioinformatics algorithm Trace edit, as similar sequences were obtained from the National Center for Biotechnology Information (NCBI) data base using BLASTN. The sequences were aligned using ClustaIX while the evolutionary history was inferred using the Neighbor- joining method in MEGA 6.0 [27]. Molecular examination using polymerase chain reaction (PCR) of the yeast revealed that the obtained ITS sequence produced an exact match during the megablast search for highly similar sequence from the NCBI non- redundant nucleotide(nr/nt) database. The evolutionary distance computed using the Jukes-Cantor method where in agreement with the phylogenetic placement of the ITS of the isolate within the Kluyveromyces species and revealed 70% closely relatedness to Kluyveromyces marxianus with ascension No; OP795959 Kluyveromyces marxianus (Figure 4 & 5).
Susceptibility test of antifungal drugs: The Kirby Bauer disc diffusion method was used for this analysis. From the stock suspension of the yeast isolates, 0.1ml cell suspension of the yeast (inoculum) equivalent to 0.05% Mcfarland standard was dispensed and evenly spread on dried surface of Sabouraud dextrose agar (oxoid) plate. After 15minutes, antifungal discs were placed onto the surface of inoculated plate and then incubated at 28°C for 3 days. The antifungal chemotherapeutic agents used for this analysis were ketoconazole, fluconazole and amphotericin B. After incubation, the diameter zone of inhibition of each drug was observed and measured [28].
The antifungal sensitivity test results showed that ketoconazole had the highest zone of inhibition on Kluyveromyces marxianus isolate showing a mean 38.5 ± 0.5 (mm) standard Deviation of diameter zone of inhibition followed by fluconazole which showed a mean 24.5±0.5 (mm) standard deviation of diameter zone of inhibition (Table 1), while the fungus was completely resistant to Amphotericin B (Figure 6).
Intervention/Treatment
Based on the antifungal sensitivity results, the patient was placed on topical and oral treatment using ketoconazole (250mg twice daily) to treat the skin lesion.
Follow-up and treatment outcome
Within the first two weeks of treatment initiation, it was observed that the lesion had dried up, leaving dried skin with a few nodes that had life in them (Figure 7a). By the end of the following two weeks (one month follow-up), the remaining small nodules were gone, leaving dried scaly skin areas (Figure 7b), which then developed clinical resistance subsequently (Figure 7c). The healing progress was scored at 50% (at 2 weeks) and 85% (at 4 weeks) by visual and lesion assessment.
Discussion
This case presented with a skin lesion that was suspected to be cutaneous candidiasis based on the physical presentation and history and was indeed confirmed to be cutaneous candidiasis caused by Kluyveromyces marxianus species which is a rare Candida species. Due to limited literature and knowledge about this rare fungus, it is difficult to ascertain the exact source in the environment from where this patient might have picked the organism up since it exists in different habitats in nature. The rise in the incidence of Kluveromyces marxianus has been reported by several studies, and its resistance to common antifungals employed raises a lot of concern in clinical practice [1, 29-34].
The patient reported malaria (which is endemic in Africa), with high cholesterol, for which he had been administered control pills at the time he visited. Based on this information, it is important to note that the patient was already on medication, which can suppress his immune system. Malaria suppresses immunity, and with our basic scientific knowledge, immunosuppression can also predispose the host to infection [35]. On the other hand, the presence of cholesterol in the serum is a serious factor in fungal infection, considering that fungi possess ergosterol, which is an active component of their cell membrane, and it is closely related to human cholesterol. It has been reported that the uptake of cholesterol by fungi from the host is an important strategy for reducing susceptibility to antifungals [36]. Another study also reported that the presence of cholesterol in the serum supports the growth of pathogenic fungi, especially after being exposed to antifungals previously [37].
Observation from one of the duplicate culture plates revealed minimal growth of mould suggestive of Aspergillus species, which was considered not significant when compared with the other colonies with heavy growth of white shiny yeast on both plates. The point growth of Aspergillus species could be as a result of environmental contamination, which could be a shortcoming in this study. Analyzing the in vitro observation of this result, it was presumed that ketoconazole might be a good choice of therapy for treating the lesion. The susceptibility of this rare Candida species to ketoconazole has been reported by previous studies [38-41].
Considering that the findings from this present study demonstrate that K. marxianus was totally resistant to amphotericin B, this agrees marginally with previous studies that reported a high minimal inhibitory concentration of K. marxianus on Amphotericin B, which implies a lower efficacy [7;11]. In another study, it was observed that itraconazole was the most potent antifungal agent against K. marxianus (formerly C. kefyr) when compared with other antifungals such as fluconazole, clotrimazole, miconazole and nystatin tested [12], which was not in agreement with our study. Some previous studies were in agreement with our findings by reporting that fluconazole, voriconazole, and caspofungin were mostly active on K. marxianusr than Amphotericin B when tested in vitro [13, 17, 39]. The poor sensitivity expressed by Amphotericin B in this study was also in agreement with other studies [17, 18], while another study reported a contrast scenario [42].
Furthermore, in a recent study, it was also reported that K. marxianus isolated from vaginal specimens expressed 92.6% and 90.7% susceptibility to Voriconazole and Ketoconazole, respectively [43], which is in line with our present findings. Based on the result obtained from this current study, the patient was placed on topical and oral treatment using ketoconazole (250mg twice daily), and the result showed incomplete healing/ clearance of the lesion even after four months. The therapeutic failure of this medication has shown that susceptibility of isolates to antimicrobials in vitro is not an assurance that the drug will be effective in vivo. The use of azoles in treating fungal infections has been a long-term clinical practice and has been reported to possess fungistatic activity against Candida species [44]. Irrespective of its effectiveness, it is also important to note that fungal resistance to antifungals, including azoles, has risen over time, and this has been attributed to overuse of these drugs on fungi, especially in sub-Saharan Africa [45, 46]. The development of resistance by microorganisms might lead to treatment failure, which could arise in isolate developing biofilms, which might lead to blockage of drug target sites.
Another important factor could be attributed to the acquisition of efflux pumps (increased export of the drug from inside the fungal cell to the exterior) or chromosomal mutation [47-49]. Other possible limiting factors to drug sensitivity are bioavailability (the level of drug that gets to the target site), pharmacokinetics, severity of infection and host immune system. To achieve successful therapeutics, the host immune system also plays a critical role, especially amongst static antifungals like azoles [45]. It is important to note that some of these factors highlighted above might have given rise to treatment failure, as was observed in this current study.
Antimicrobial resistance is a major public health challenge, especially in clinical practice, as this has given rise to high morbidity, mortality and increased treatment cost. In this present study, its impact has been observed through treatment failure and complications. Considering that antimicrobial resistance is an increasing global public health pandemic, there is a need for urgent development strategies and interventions to combat it. Therefore, in this present study, there is a need for further studies to be carried out on this fungus, due to limitations encountered using a single case study, which limited the follow-up of the case, classes of antimycotic drugs used, diagnostic methods, such as minimum inhibitory concentration (MIC) of the drug used, etc. Nevertheless, there is no clinical laboratory breakpoint by CLSI present for Ketoconazole [50].
Conclusion
This study has shown that cutaneous candidiasis is still a threat especially amongst non- Candida albicans species. Considering the emergence of in-vitro and in-vivo disparity of this fungal isolate against a commonly used antimycotic drug tested in this study, there is need for elaborate research on this pathogen and development of newer antifungals as this will help in handling and addressing future occurrences and management strategies of disease treatment. This study also has demonstrated that the therapeutic efficacy of drugs is determined by a wide range of factors, so there is need for further research efforts to address these problems.
| Antifungal | Zone of inhibition (duplicate) | Mean ± SD |
|---|---|---|
| Ketoconazole | 39 (38) | 38.5 ± 0.5 |
| Fluconazole | 25 (24) | 24.5 ± 0.5 |
| Amphotericine B | 0 (0) | 0 |

References
- Rosani SN, Sri V, Safruddin A, Dirmawati K, Widyawati D, Anni A. Cutaneous candidiasis caused by Candida kefyr. Pan Afr Med J [Internet]. 2021 [cited 2025 Oct 8];38:178. Available from: https://www.panafrican-med-journal.com/content/article/38/178/full. doi: 10.11604/pamj.2021.38.178.28054.
- Enzo P, Maurizio N, Grazia Z, Valeria D, Mattia C, Eleonora C, Donatella MR, Alessia B, Caria P, Cecilia A, Daniela S, Valeria P, Daniela F, Vincenzo P. Cutaneous candidiasis caused by Candida albicans in a young non-immunosuppressed patient: an unusual presentation. Int J Immunopathol Pharmacol [Internet]. 2018 [cited 2025 Oct 8];32:2058738418781368. Available from: https://journals.sagepub.com/doi/10.1177/2058738418781368. doi: 10.1177/2058738418781368.
- Keshay L, Nabaraj A, Anup B, Lina D, Parmananda B, Binad D, Upendra TS, Bipin A, Megha RB, Kamal RR, Prakash G. Biofilm-producing Candida species causing oropharyngeal candidiasis in HIV patients attending Sukraraj Tropical and Infectious Diseases Hospital in Kathmandu, Nepal. HIV AIDS (Auckl) [Internet]. 2020 [cited 2025 Oct 8];12:211-20. Available from: https://www.dovepress.com/biofilm-producing-candida-species-causing-oropharyngeal-candidiasis-in-peer-reviewed-article-HIV. doi: 10.2147/HIV.S255698.
- Richardson JP, Naglik JR. Special issue: mucosal fungal infections. J Fungi (Basel) [Internet]. 2018 [cited 2025 Oct 8];4(2):43. Available from: https://www.mdpi.com/2309-608X/4/2/43. doi: 10.3390/jof4020043.
- Antachopoulos C. Invasive fungal infections in congenital immunodeficiencies. Clin Microbiol Infect [Internet]. 2010 Sep [cited 2025 Oct 8];16(9):1335-42. Available from: https://www.clinicalmicrobiologyandinfection.com/article/S1198-743X(14)61345-0/fulltext. doi: 10.1111/j.1469-0691.2010.03289.x.
- Heidrich D, Stopiglia CD, Magagnin CM, Daboit TC, Vettorato G, Amaro TG, Scroferneker ML. Sixteen years of dermatomycosis caused by Candida species in the metropolitan area of Porto Alegre, Southern Brazil. Rev Inst Med Trop Sao Paulo [Internet]. 2016 [cited 2025 Oct 8];58:14. Available from: https://www.revistas.usp.br/rimtsp/article/view/112829. doi: 10.1590/S1678-9946201658014.
- Sadeghi G, Ebrahimi-Rad M, Shams-Ghahfarokhi M, Jahanshiri Z, Ardakani EM, Eslamifar A, Mousavi SF, Razzaghi-Abyaneh M. Cutaneous candidiasis in Tehran-Iran: from epidemiology to multilocus sequence types, virulence factors and antifungal susceptibility of etiologic Candida species. Iran J Microbiol [Internet]. 2019 Aug [cited 2025 Oct 8];11(4):267-79. Available from: https://ijm.tums.ac.ir/index.php/ijm/article/view/2166.
- Pitchumoni CS, Dharmarajan T. Geriatric gastroenterology. New York: Springer Science+Business Media; 2012.
- Pfaller MA, Diekema DJ, Turnidge JD, Castanheira M, Jones RN. Twenty years of the SENTRY Antifungal Surveillance Program: results for Candida species from 1997-2016. Open Forum Infect Dis [Internet]. 2019 Mar [cited 2025 Oct 8];6(Suppl 1):S79-94. Available from: https://academic.oup.com/ofid/article/6/Supplement_1/S79/5381491. doi: 10.1093/ofid/ofy358.
- Dufresne SF, Marr KA, Sydnor E, Staab JF, Karp JE, Lu K, Zhang SX, Lavallée C, Perl TM, Neofytos D. Epidemiology of Candida kefyr in patients with hematologic malignancies. J Clin Microbiol [Internet]. 2014 Jun [cited 2025 Oct 8];52(6):1830-7. Available from: https://journals.asm.org/doi/10.1128/JCM.00131-14. doi: 10.1128/JCM.00131-14.
- Atalay MA, Koc AN, Çakır N, Şengüzel FM, Sağiroğlu P. The investigation of antifungal susceptibilities of Kluyveromyces marxianus and Clavispora lusitaniae strains isolated from various clinical specimens. J Surg Med [Internet]. 2021 [cited 2025 Oct 8];5(11):1104-6. Available from: https://jsurgmed.com/article/view/892965. doi: 10.28982/josam.892965.
- Halawi MH, Nasser R, Yassine W, Yusef H, Borjac J, Zeaiter Z. First case of identification of Candida kefyr and Pichia kluyveri in Lebanese water. Water Air Soil Pollut [Internet]. 2020 [cited 2025 Oct 8];231:108. Available from: https://link.springer.com/article/10.1007/s11270-020-04460-y. doi: 10.1007/s11270-020-04460-y.
- Ahmad S, Khan Z, Al-Sweih N, Alfouzan W, Joseph L, Asadzadeh M. Candida kefyr in Kuwait: prevalence, antifungal drug susceptibility, and genotypic heterogeneity. PLoS One [Internet]. 2020 [cited 2025 Oct 8];15(10):e0240426. Available from: https://journals.plos.org/plosone/article?id=10.1371/journal.pone.0240426. doi: 10.1371/journal.pone.0240426.
- Zahra Z, Samin KI, Maryam R, Kamiar Z. Antifungal drug susceptibility profile of Candida kefyr isolated from clinical samples and dairy products. Can J Infect Dis Med Microbiol [Internet]. 2024 [cited 2025 Oct 8];2024:6594366. Available from: https://www.hindawi.com/journals/cjidmm/2024/6594366/. doi: 10.1155/2024/6594366.
- Syed S, Amir A, Abbas MW, Ishtiaq S, Ali H, Ahmad SA. Systemic candidiasis by Candida kefyr: case series from Pakistan. J Med Case Rep Case Ser [Internet]. 2023 [cited 2025 Oct 8];4(6):APR04060437. Available from: https://www.acquaintpublications.com/article/systemic_candidiasis_by_candida_kefyr_case_series_from_pakistan. doi: 10.38207/JMCRCS/2023/APR04060437.
- Spiliopoulou A, Kolonitsiou F, Vrioni G, Tsoupra S, Lekkou A, Paliogianni F. Invasive Candida kefyr infection presenting as pyelonephritis in an ICU hospitalized COVID-19 patient: case report and review of the literature. J Mycol Med [Internet]. 2022 May [cited 2025 Oct 8];32(2):101236. Available from: https://www.sciencedirect.com/science/article/pii/S1156523321001912. doi: 10.1016/j.mycmed.2021.101236.
- Turk Dagi H, Findik D, Senkeles C, Arslan U. Identification and antifungal susceptibility of Candida species isolated from bloodstream infections in Konya, Turkey. Ann Clin Microbiol Antimicrob [Internet]. 2016 [cited 2025 Oct 8];15:36. Available from: https://ann-clinmicrob.biomedcentral.com/articles/10.1186/s12941-016-0153-1. doi: 10.1186/s12941-016-0153-1.
- Nagy F, Bozó A, Tóth Z, Daróczi L, Majoros L, Kovács R. In vitro antifungal susceptibility patterns of planktonic and sessile Candida kefyr clinical isolates. Med Mycol [Internet]. 2018 Jun 1 [cited 2025 Oct 8];56(4):493-500. Available from: https://academic.oup.com/mmy/article/56/4/493/4562624. doi: 10.1093/mmy/myx080.
- Furong Z, Shujun M, Sujiang T, Ying W, Min L. Clinical characteristics and drug resistance analysis of 8 cases of Kluyveromyces marxianus (Candida kefyr) infection. Chin J Dermatol [Internet]. 2024 [cited 2025 Oct 8];57(4):338-42. Available from: https://www.cjd.org.cn/en/article/doi/10.35541/cjd.20230214. doi: 10.35541/cjd.20230214.
- Mishra R, Mishra PS, Varshney S, Mazumder R, Mazumder A. In-vitro and in-vivo approaches for screening the potential of anticancer agents: a review. Curr Drug Discov Technol [Internet]. 2022 [cited 2025 Oct 8];19(3):e060122200071. Available from: https://www.eurekaselect.com/article/120463. doi: 10.2174/1570163819666220106122811.
- Komatsu T, Yamanaka S, Oshima H, Hayashi K. In-vitro and in-vivo experiments can lead to opposite conclusions: a consideration from a series of experiments on the relationship between throbber rotation speed and perceived waiting time. Int J Hum Comput Interact [Internet]. 2025 [cited 2025 Oct 8];41(15):1-15. Available from: https://www.tandfonline.com/doi/full/10.1080/10447318.2024.2492806. doi: 10.1080/10447318.2024.2492806.
- Xu Y, Shrestha N, Préat V, Beloqui A. An overview of in vitro, ex vivo, and in vivo models for studying the transport of drugs across intestinal barriers. Adv Drug Deliv Rev [Internet]. 2021 Aug [cited 2025 Oct 8];175:113795. Available from: https://www.sciencedirect.com/science/article/pii/S0169409X21001813. doi: 10.1016/j.addr.2021.05.005.
- Bouopda Tamo SP. Candida infections: clinical features, diagnosis and treatment. Infect Dis Clin Microbiol [Internet]. 2020 [cited 2025 Oct 8];2:91-102. Available from: https://www.idcmjournal.org/candida-infections. doi: 10.36519/idcm.2020.0006.
- Infectious Diseases Society of America. Clinical practice guidelines for the management of candidiasis: 2022 update by the Infectious Diseases Society of America. Clin Infect Dis [Internet]. 2022 [cited 2025 Oct 8]. Available from: https://www.idsociety.org/practice-guideline/candidiasis.
- Cheesbrough M. District laboratory practice in tropical countries, part 2. 2nd ed., update. Cambridge: Tropical Health Technology/Butterworths; 2010.
- Osama EA, Mohamed AM, AbdEl-Rahim MA, El-Samawaty A, Shaban RMS. Non-liquid nitrogen-based method for isolation of DNA from filamentous fungi. Afr J Biotechnol [Internet]. 2011 Oct [cited 2025 Oct 8];10(65):14337-41. Available from: https://www.ajol.info/index.php/ajb/article/view/73642. doi: 10.5897/AJB11.1673.
- Saitou N, Nei M. The neighbor-joining method: a new method for reconstructing phylogenetic trees. Mol Biol Evol [Internet]. 1987 Jul [cited 2025 Oct 8];4(4):406-25. Available from: https://academic.oup.com/mbe/article/4/4/406/1036632. doi: 10.1093/oxfordjournals.molbev.a040454.
- Kirby WM, Bauer AW. Antibiotic susceptibility testing by a standardized single disk method. Am J Clin Pathol [Internet]. 1966 Apr [cited 2025 Oct 8];45(4):493-6. Available from: https://academic.oup.com/ajcp/article-abstract/45/4_ts/493/4829456.
- Kumar S, Kumar A, Roudbary M, Mohammadi R, Černáková L, Rodrigues CF. Overview on the infections related to rare Candida species. Pathogens [Internet]. 2022 Aug [cited 2025 Oct 8];11(9):963. Available from: https://www.mdpi.com/2076-0817/11/9/963. doi: 10.3390/pathogens11090963.
- Seth-Smith HMB, Büchler AC, Hinic V, Medinger M, Widmer AF, Egli A. Bloodstream infection with Candida kefyr/Kluyveromyces marxianus: case report and draft genome. Clin Microbiol Infect [Internet]. 2020 Apr [cited 2025 Oct 8];26(4):522-4. Available from: https://www.clinicalmicrobiologyandinfection.com/article/S1198-743X(19)30641-1/fulltext. doi: 10.1016/j.cmi.2019.11.019.
- Ökmen F, Ekici H, Ari SA. Case report of a tubo-ovarian abscess caused by Candida kefyr. J Obstet Gynaecol Can [Internet]. 2018 Nov [cited 2025 Oct 8];40(11):1466-7. Available from: https://www.jogc.com/article/S1701-2163(18)30082-8/fulltext. doi: 10.1016/j.jogc.2018.02.007.
- Arastehfar A, Daneshnia F, Farahyar S, Fang W, Salimi M, Salehi M, Hagen F, Pan W, Roudbary M, Boekhout T. Incidence and spectrum of yeast species isolated from the oral cavity of Iranian patients suffering from hematological malignancies. J Oral Microbiol [Internet]. 2019 [cited 2025 Oct 8];11(1):1601061. Available from: https://www.tandfonline.com/doi/full/10.1080/20002297.2019.1601061. doi: 10.1080/20002297.2019.1601061.
- Charsizadeh A, Mirhendi H, Nikmanesh B, Eshaghi H, Rahmani M, Farhang A, Bakhshi H, Makimura K. Candidemia in children caused by uncommon species of Candida. Arch Pediatr Infect Dis [Internet]. 2018 [cited 2025 Oct 8];6(2):e11895. Available from: https://brieflands.com/articles/archcid-11895.html. doi: 10.5812/pedinfect.11895.
- Husni R, Zerdan MB, Samaha N, Helou M, Mahfouz Y, Saniour R, Hourani S, Kolanjian H, Afif C, Azar E, Jisr T, Mokhbat J, Abboud E, Feghali R, Matta H, Karayakouboglo G, Matar M, Moghnieh R, Daoud Z. Characterization and susceptibility of non-albicans Candida isolated from various clinical specimens in Lebanese hospitals. Front Public Health [Internet]. 2023 [cited 2025 Oct 8];11:1115055. Available from: https://www.frontiersin.org/articles/10.3389/fpubh.2023.1115055/full. doi: 10.3389/fpubh.2023.1115055.
- Calle CL, Mordmüller B, Singh A. Immunosuppression in malaria: do Plasmodium falciparum parasites hijack the host? Pathogens [Internet]. 2021 Oct [cited 2025 Oct 8];10(10):1277. Available from: https://www.mdpi.com/2076-0817/10/10/1277. doi: 10.3390/pathogens10101277.
- Okamoto M, Takahashi-Nakaguchi A, Tejima K, Sasamoto K, Yamaguchi M, Aoyama T, Nagi M, Tanabe K, Miyazaki Y, Nakayama H, Sasakawa C, Kajiwara S, Brown AJP, Teixeira MC, Chibana H. Erg25 controls host-cholesterol uptake mediated by Aus1p-associated sterol-rich membrane domains in Candida glabrata. Front Cell Dev Biol [Internet]. 2022 [cited 2025 Oct 8];10:820675. Available from: https://www.frontiersin.org/articles/10.3389/fcell.2022.820675/full. doi: 10.3389/fcell.2022.820675.
- Nagi M, Tanabe K, Yamagoe S, Umeyama T, Ohno H, Miyazaki Y, Oura T, Kajiwara S, Nakayama H. Serum cholesterol promotes the growth of Candida glabrata in the presence of fluconazole. J Infect Chemother [Internet]. 2013 Feb [cited 2025 Oct 8];19(1):138-43. Available from: https://www.sciencedirect.com/science/article/pii/S1341321X12003543. doi: 10.1007/s10156-012-0531-3.
- Fornari G, Vicente VA, Gomes RR, Muro MD, Pinheiro RL, Ferrari C, Herkert PF, Takimura M, de Newton CS, Veiroz-Telles F. Susceptibility and molecular characterization of Candida species from patients with vulvovaginitis. Braz J Microbiol [Internet]. 2016 Apr-Jun [cited 2025 Oct 8];47(2):373-80. Available from: https://www.scielo.br/j/bjm/a/5Q6Y7Y3B9J7J7J7J7J7J7J7. doi: 10.1016/j.bjm.2016.01.005.
- Gębska A, Garbacz K, Żiółkowska-Klinkosz M, Wierzbowska M, Kwapińska E. Screening for antifungal susceptibility of oral Candida albicans and non-albicans Candida species. Acad J Sci Res [Internet]. 2019 [cited 2025 Oct 8];7(8):434-8. Available from: https://www.academiapublishing.org/journals/ajsr/pdf/2019/August/Gebska%20et%20al.pdf. doi: 10.15413/ajsr.2019.0150.
- Sylla K, Tine RC, Ndiaye LA, Sow D, Lelo S, Dia M, Faye B, Dieng T. Distribution of Candida species and their susceptibility to antifungal drugs in Dakar, Senegal. Int J Infect Dis Ther [Internet]. 2019 [cited 2025 Oct 8];4(4):50-5. Available from: https://www.sciencepublishinggroup.com/article/10.11648/j.ijidt.20190404.11. doi: 10.11648/j.ijidt.20190404.11.
- Singh L, Harakuni SU, Basnet B, Parajuli K. Speciation and antifungal susceptibility testing of Candida species isolated from clinical samples. Asian J Med Sci [Internet]. 2020 Jul [cited 2025 Oct 8];11(4):30-4. Available from: https://www.nepjol.info/index.php/AJMS/article/view/28494. doi: 10.3126/ajms.v11i4.28494.
- Megha S, Arunaloke C. Candidiasis and other emerging yeasts. Curr Fungal Infect Rep [Internet]. 2023 [cited 2025 Oct 8];17(1):15-24. Available from: https://link.springer.com/article/10.1007/s12281-023-00455-3. doi: 10.1007/s12281-023-00455-3.
- Zarrinfar H, Kord Z, Fata A. High incidence of azole resistance among Candida albicans and C. glabrata in Northeastern Iran. Curr Med Mycol [Internet]. 2021 Sep [cited 2025 Oct 8];7(3):18-21. Available from: https://cmjournal.mums.ac.ir/article_17801.html. doi: 10.18502/cmm.7.3.7801.
- Rodrigues CF, Henriques M. Oral mucositis caused by Candida glabrata biofilms: failure of the concomitant use of fluconazole and ascorbic acid. Ther Adv Infect Dis [Internet]. 2017 Jan [cited 2025 Oct 8];4(1):10-7. Available from: https://journals.sagepub.com/doi/10.1177/2049936116684477. doi: 10.1177/2049936116684477.
- Gaye FH, Fahriye E, Mehmet E, Gürol MU. An epidemiologic analysis of vulvovaginal candidiasis and antifungal susceptibilities. Infect Microb Dis [Internet]. 2022 Sep [cited 2025 Oct 8];4(3):131-6. Available from: https://journals.lww.com/imd/fulltext/2022/09000/an_epidemiologic_analysis_of_vulvovaginal.6.aspx. doi: 10.1097/IM9.0000000000000095.
- Robbins N, Caplan T, Cowen LE. Molecular evolution of antifungal drug resistance. Annu Rev Microbiol [Internet]. 2017 Sep 8 [cited 2025 Oct 8];71:753-75. Available from: https://www.annualreviews.org/doi/10.1146/annurev-micro-030117-020345. doi: 10.1146/annurev-micro-030117-020345.
- Bhattacharya S, Sae-Tia S, Fries BC. Candidiasis and mechanisms of antifungal resistance. Antibiotics [Internet]. 2020 Jun [cited 2025 Oct 8];9(6):312. Available from: https://www.mdpi.com/2079-6382/9/6/312. doi: 10.3390/antibiotics9060312.
- Boakye-Yiadom E, Odoom A, Osman AH, Ntim OK, Kotey FCN, Ocansey BK, Donkor ES. Fungal infections, treatment, and antifungal resistance: the sub-Saharan African context. Ther Adv Infect Dis [Internet]. 2024 [cited 2025 Oct 8];11:20499361241297525. Available from: https://journals.sagepub.com/doi/10.1177/20499361241297525. doi: 10.1177/20499361241297525.
- Denning DW. Antifungal drug resistance: an update. Eur J Hosp Pharm [Internet]. 2022 Mar [cited 2025 Oct 8];29(2):109-12. Available from: https://ejhp.bmj.com/content/29/2/109. doi: 10.1136/ejhpharm-2021-003075.
- Clinical and Laboratory Standards Institute. Current issues related to antimicrobial susceptibility testing (AST) and reporting. CLSI AST Subcommittee Meetings [Internet]. 2023 [cited 2025 Oct 8]. Available from: https://clsi.org/meetings/ast-subcommittee-meetings/.
